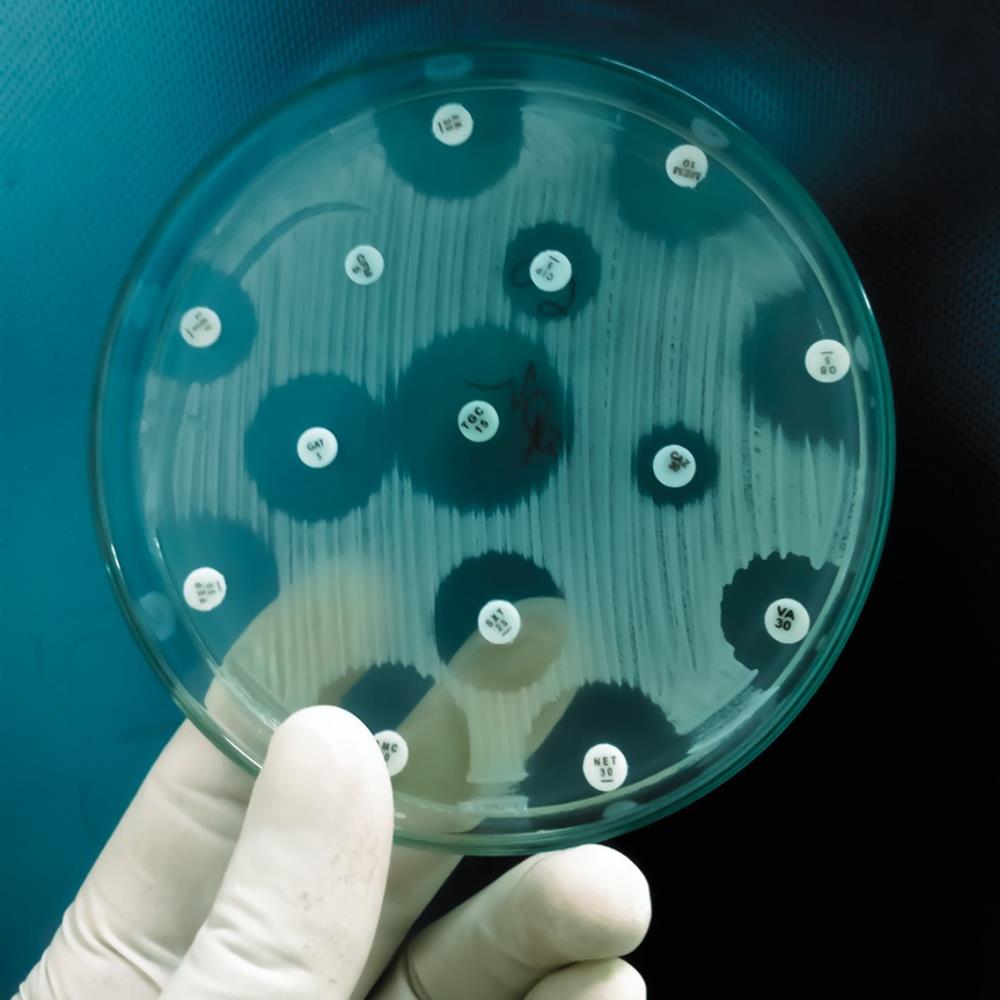

Overview
Antibiotic research and development have not met the urgent need for new antibiotics. While financial incentives and market reforms are critical for sustainable progress on the issue, addressing regulatory hurdles to accelerate approval of new antibiotics can also help their development and improve their access in emerging markets. One Health Trust researchers conducted a landscape analysis to study the current climate for antimicrobial innovation, focusing on regulatory challenges and opportunities for the approval of new antibiotics in Brazil, India, and South Africa.

The Study
An assessment of the current state of antibiotic development paints an alarming picture: of failing markets resulting from slow clinical uptake of drugs, relatively small numbers of target infections to support existing drugs economically, slow clinical uptake, and redundant drugs in the pipeline. Despite some improvement in the past decade, pharmaceutical research and development have not responded adequately to the growing need for new antibiotics.
Financial incentives and market reforms are needed but lowering regulatory hurdles to the approval of new antibiotics could also help promote the development of new drugs. To assess regulatory challenges and opportunities, One Health Trust, with support from the AMR Industry Alliance, conducted a landscape analysis of the current framework for antibiotic approval in Brazil, India, and South Africa.
The analysis was informed by organizational reports, peer-reviewed literature, press releases, and other sources. Semistructured interviews with scientists, regulators, and experts from international organizations in the three countries were conducted between November 2021 and February 2022 to obtain global and national perspectives on regulatory hurdles and the potential for innovation.
“Much remains to be done to improve how we use antibiotics globally and to reduce the need for antibiotics through vaccines, water and sanitation, and infection prevention. But these will not be sufficient. The growing burden of AMR will need to be addressed with new antibiotics. Unless we significantly rethink and revise current processes for regulatory approvals, the burden of AMR will keep increasing.”
– Dr. Ramanan Laxminarayan, Director, One Health Trust

Recommendations to Accelerate the Approval of Antibiotics
- In the regulatory framework, create an accelerated approval pathway for critical antimicrobials—those that target serious and life-threatening infections, such as multidrug-resistant infections.
- Leverage existing programs for expedited approval of drugs targeting TB, HIV, and COVID-19 to accelerate the approval of critical antimicrobials.
- Increase regulatory authorities’ capacity to deal with the complexity of AMR and novel clinical trials.
- Increase regulatory harmonization to facilitate the accelerated approval of critical antimicrobials.
“Simply developing new antibiotics without registering them in all countries where patients are in need wastes the significant resources that go into new antibiotic development and denies companies access to key markets that could make new antibiotic development more financially rewarding than it currently is.”
– Dr. Ramanan Laxminarayan, Directory, One Health Trust

Partner
AMR Industry Alliance (AMRIA)
Publication
Erta Kalanxhi, Giridara Gopal Parameswaran, Max Van Wijk, Rati Kapoor, Gilbert Osena, Jyoti Joshi, and Ramanan Laxminarayan (2022) Drug Regulatory Approvals and Opportunities for Antimicrobial Innovation – Perspectives from Brazil, India, and South Africa. Washington, DC: One Health Trust.
Download the report here.






